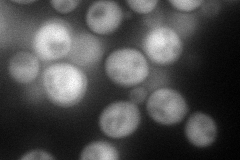
YLL060C
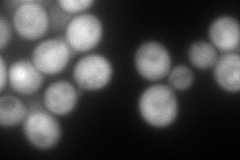
YLL060C
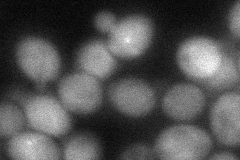
YLL060C

View description
Glutathione S-transferase capable of homodimerization; functional overlap with Gtt2p, Grx1p, and Grx2p
Localization:
Intensity:
Fold change:
Significance:
-
C’ GFP library in SD

cytosol18.35 -
N' NOP1pr-GFP in SD
cytosol117.35 -
N' TEF2pr-mCherry in SD
cytosol207.968 -
N' NATIVEpr-GFP in SD

cytosol17.6782 -
N' TEF2pr-VC and Cyto-VN in SD
cytosol59.4909 -
C’ GFP library in SD+DTT

cytosol17.230.93No -
C’ GFP library in SD+H2O2

cytosol33.951.84No -
C’ GFP library in Starvation Media

cytosol34.651.88No -
C’ GFP library on the background of Pup2-DaMP

cytosol -
C’ GFP library on the background of CCT mutant

cytosol17.42410.949189No
